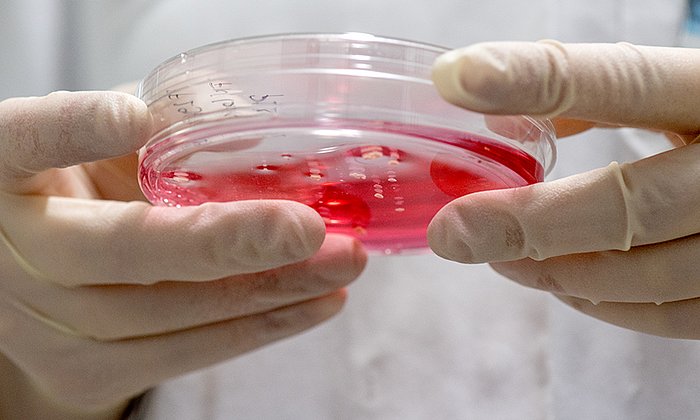
Arbeiten mit Zellkulturen sind in der onkologischen Grundlagenforschung ein wichtiges Werkzeug. (Bild: A. Heddergott / TUM)

Wichtigster deutscher Forschungspreis für Prof. Ruland
Krebsforscher erhält Leibniz-Preis

Prof. Ruland konzentriert sich auf normale und bei Krankheit gestörte Signalprozesse im Immunsystem. Mit seiner Arbeitsgruppe untersucht er, wie Immunzellen Krankheitserreger erkennen, die Immunabwehr einleiten und wie krankhaft veränderte Signale in Blutzellen zur Entstehung von Krebserkrankungen führen. Ziel ist es, Grundlagen zur therapeutischen Manipulation des Immunsystems zu liefern. Zu seinen wichtigsten wissenschaftlichen Erkenntnissen gehört ein 2017 von ihm und seinem Team entdeckter „Not-Aus“-Schalter für fehlerhafte Zellen.
TUM-Präsident Prof. Thomas F. Hofmann würdigte die herausragende Arbeit des Preisträgers: „Prof. Ruland ist einer der bedeutendsten Krebsforscher unserer Zeit. Mit seiner Forschung versucht er, die Selbstheilungskräfte des Körpers auf molekularer Ebene besser zu verstehen und so Krankheiten wie Leukämie und Lymphome zu bekämpfen. Wir sind stolz, ihn in unseren Reihen zu haben, denn er verkörpert den hohen Anspruch der TUM: Internationale Spitzenforschung kombiniert mit praktischem Nutzen für die Menschen.“
Prof. Ruland studierte Medizin in Gießen und Pittsburgh und promovierte in Pharmakologie. Nach ärztlicher und wissenschaftlicher Tätigkeit an der TUM, der Universität Freiburg, am Ontario Cancer Institute und dem AMGEN Research Institute der University of Toronto leitete er ab 2003 eine Nachwuchsgruppe der Deutschen Krebshilfe an der TUM. Er habilitierte 2005 in Medizin und war von 2010 bis 2012 Ordinarius für Molekulare Immunologie an der TUM. Seit 2012 ist er Ordinarius für Klinische Chemie. Er ist Mitglied der Nationalen Akademie der Wissenschaften Leopoldina und der Bayerischen Akademie der Wissenschaften. Seit 2018 ist er Sprecher des DFG-Sonderforschungsbereichs 1335 „Aberrante Immunsignale bei Krebserkrankungen“.
Ruland erhielt bereits zahlreiche Auszeichnungen und Förderungen für seine wissenschaftliche Arbeit, unter anderem:
- European Research Council Advanced Grant (2013 & 2019)
- Paul-Martini-Preis (2010)
- Wilhelm-Warner-Preis für Krebsforschung (2010)
- Wissenschaftspreis der Arbeitsgemeinschaft für Internistische Onkologie (2007)
- Artur-Pappenheim-Preis der Deutschen Gesellschaft für Hämatologie und Onkologie (2006)
Auch im vergangenen Jahr waren zwei Forscher der TUM mit dem Leibniz-Preis ausgezeichnet worden.
Insgesamt wurden inklusive Prof. Ruland seit 1986 bereits 23 Forscherinnen und Forscher der TUM mit Leibniz-Preisen geehrt.
Kontakte zum Artikel:
Prof. Dr. Jürgen Ruland
Technische Universität München
Lehrstuhl für Klinische Chemie und Pathobiochemie
Tel.: +49 89 4140 4751
j.ruland@tum.de